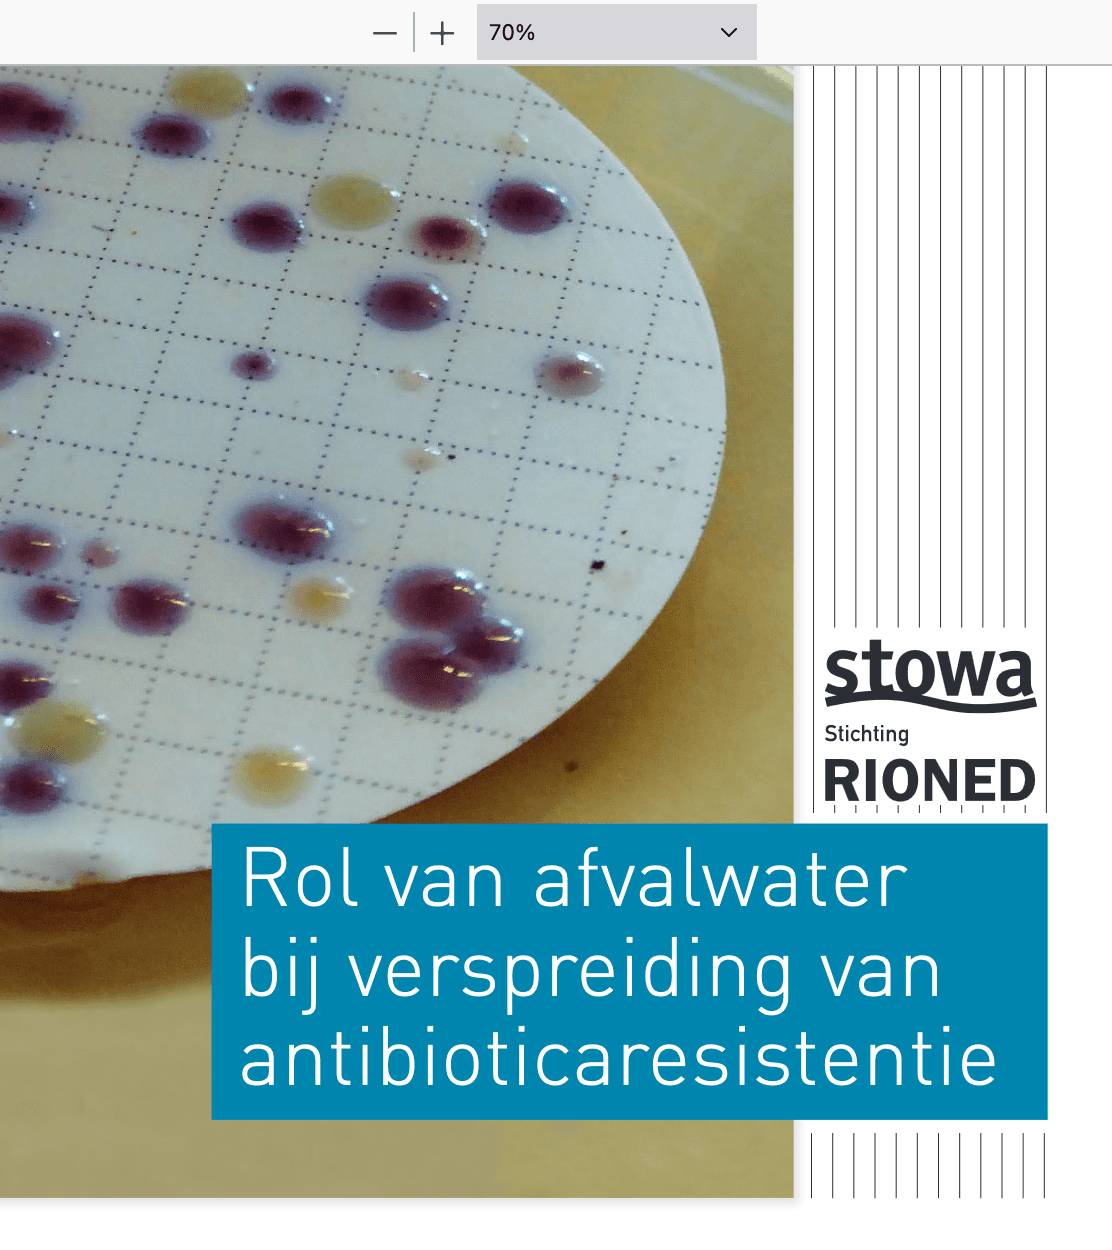
Rol Van Afvalwater Bij Verspreiding Van Antibioticaresistentie

Deze publicatie geeft de resultaten van het eerste Nederlandse onderzoek naar de belangrijkste routes voor verspreiding van resistente bacteriën naar het waterige milieu. Deze kennis is van belang voor een gefundeerde keuze over mogelijke maatregelen ter beperking van de antibioticaresistentie.
Vakpublicaties
Rol van afvalwater bij verspreiding van antibioticaresistentie (2018)
- Publicatiedatum
- 29 maart 2018

Deel artikel